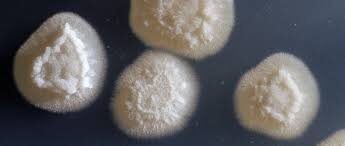

Yarrowia lipolytica; ismi, 1980 yılında van der Walt ve von Arx tarafından, yeni bir cinsi tanımlayan David Yarrow’a ithafen verilen bir mayadır. Lipolytica ismi ise yağı parçalayabildiği için verilmiştir.

Geleceğin süper mayası, çoğu hidrofobik substratı parçalayabilme özelliğiyle protein ve peptitler, amino asitler, eser mineraller (vücutta çok az miktarda ihtiyaç duyulan elementler), vitaminler (canlı metabolizmasını düzenleyen organik moleküller), karbonhidratlar (vücudun temel enerji kaynağı) ve çoğunlukla tekli doymamış yağ asitlerinden oluşan tek hücre yağı (SCO)1 gibi değerli metabolik ürünü oluşturabilmektedir. Doğada yaygın olarak bulunmaktadır. Su, toprak, yağ içeren atıklar; kanalizasyon, yüksek tuzlu ortamlar gibi çok farklı yerlerden elde edilebilmektedir. Yüksek yağ ve protein içeren birçok besinde doğal olarak yer almaktadır.
- Cheddar peynirinde;
- süt, krema, kefir, yoğurt, tereyağ gibi süt ürünlerinde;
- salam gibi fermente et ürünlerinde;
- meyve, meyve suyu, konsantre, deniz ürünleri, mayonez ve şarapta bulunmaktadır.
Ayrıca, normal bir insanın mikrobiyotasında olan bir mikroorganizmadır. Sağlıklı bireylerin solunum, sindirim sistemlerinde ve derilerinde bulunabilmektedir.
Neden Bu Kadar Besleyici?
Nüfus artışıyla birlikte protein açısından zengin olan besinlere ihtiyaç artmaktadır. Alternatif protein kaynakları üzerine araştırmalar yapılmaktadır. Y. lipolytica depo ettiği yağları parçalar ve kaliteli protein üretebilmesini sağlar. Sonuç olarak süper mayanın gelecekte bu besin açığını kapatabileceği düşünülmektedir.
EFSA (Avrupa Gıda Güvenliği Otoritesi) ve FAO (Gıda ve Tarım Örgütü), bir yetişkinin günlük ihtiyacı olan protein miktarını 50 mg olarak belirlemiştir. Y.lipolytica’nın ürettiği toplam metabolik ürünlerin ortalama olarak %43’ünü proteinler oluşturmaktadır. Yani 100 gram Y.lipolytica tozu, bir günlük protein miktarını neredeyse karşılamaktadır.
Üretimini sağladığı metabolik ürünler arasında mineraller (vücutta çok az miktarda ihtiyaç duyulan elementler) ve vitaminler (canlı metabolizmasını düzenleyen organik moleküller) de yer almaktadır:
Bu mineraller:
- Kalsiyum
- Bakır
- Fosfor
- Potasyum
- Çinko
- Krom
- İyot
- Selenyum
Vitaminler: B vitaminlerince zengindir. Suda çözündüklerinden dolayı düzenli olarak vücuda alımları zorunludur. Bu nedenle Y.lipolytica önemli bir kaynaktır.
- B1 (Tiamin)
- B2 (Riboflavin)
- B6 (Piridoksin)
- B7 (Biotin)
- B9 (Folik asit)
- B12 (Kobalamin)
Atıklardan Sofraya: Sürdürülebilir Üretim
Süper maya, sürdürülebilir bir gelecek için önemli bir kaynaktır. Çeşitli atıkları parçalayarak çevreye değer katar. Bu maya aşağıdaki atıkların çeşitli metabolitlere dönüştürülmesini sağlar:
- Alkanlar (metan, etan, propan)
- Petrol yan ürünleri (dizel, benzin, gazyağı)
- Gliserol
- Bitkisel ve hayvansal yağ atıklar
Y.Lipolytica insan mikrobiyotasında da doğal olarak bulunmaktadır. Bu da sindirimin insan ve hayvanlarda kolay olmasını sağlamaktadır. %72,3 – %77,2 oranıyla oldukça yüksek sindirilebilirlik değeri vardır. Kimyasal bileşimi, insan ve hayvan mikroorganizmasında bulunan; günümüzde bira yapımında, fırıncılıkta çokça kullanılan bir maya olan, ”Saccharomyces cerevisiae” ile oldukça benzerdir.
Fareler ve domuzlar üzerinde yapılan çalışmalarda, iki mayanın da sindirilebilirlik açısından yakın değerlerde olduğu bulunmuştur fakat tereyağı özütü açısından Y.lipolytica‘nın sindirilebilirlik oranı %57,3 iken bira mayasının neredeyse sıfırdır.
Yağların Parçalanmasını Sağlayan Enzimler
LİPAZLAR (LIP2, LIP7, LIP8 vb.): Trigiliseritleri yağ asitlerine parçalar.

Acyl-Coa OKSİDAZLAR (POX1-POX6): Yağ asitlerini Beta-oksidasyonla tamamen parçalarlar.

CYP52 AİLESİ (P450 ENZİMLERİ): Alkan ve yağ asitlerini hidroksilleyerek (-OH eklenerek) metabolizmanın, oluşum ve yıkımların, başlamasını sağlamaktadır.

Sağlığımıza Zarar Verir mi?
1950 ‘lerde Britanya Petrol Şirketi bu mayayı hayvan yemi için tek hücre proteini (SCP) üretiminde kullanmıştır. Büyümeyi destekleyen ve bağışıklık güçlendirici özelliği keşfedilerek 2010’dan beri Avrupa Birliği’nde biyoyakıt artıklarında yetiştirilen süper maya hayvan beslenmesinde kullanılmaktadır.
Bu mayanın optimal kültür koşulları yani maksimum verim elde edilebilen büyüme koşulları:
- pH 5.5
- 28°C ile 30°C arası sıcaklık
- oksijenli ortam koşullarıdır.
32°C ‘nin üzerinde yaşamını sürdüremeyen süper maya, insan tüketimi açısından güvenli olabileceğini EFSA (Avrupa Gıda Güvenliği Otoritesi) tarafından alınan karalar ile kanıtlanmıştır.
Bilim İnsanlarının 1 Numaralı Tercihi
Genetik mühendisliği açısından kullanımı kolay olması sebebiyle bilim insanlarının çalışmayı sevdiği bir mikroorganizmadır. Genetik olarak suşları geliştirerek (metabolik yolakların düzenlenmesi, yeni enzimlerin eklenmesi) atık maddelerin istenilen değerli ürüne dönüşümü sağlanabilmektedir.
- Bir çok metabolik ürün oluşturabilmesi,
- Kolay kültüre edilebilmesi,
- İnsan ve hayvan mikrobiyotasında doğal olarak bulunması,
- Üzerinde bir çok çalışmanın yapıldığı bira mayası ile benzer özellikler göstermesi,
- Atık maddelerin değerli bileşenlere dönüşümünü sağlayarak sürdürebilirliğe katkıda bulunması gibi özellikler Y.lipolytica’nın kullanımını ve verimini pozitif yönde etkilemektedir.
Güvenilirliği kanıtlanmış, çevre dostu olan süper maya gelecekte başlıca protein kaynaklarından biri olacak gibi görünüyor. Hem besleyici hem de düzenleyici etkilere sahip olması tercih edilebilirliğini arttırmaktadır.
Kaynak
Yarrowia lipolytica as an Alternative and Valuable Source of Nutritional and Bioactive Compounds for Humans
Agboola, J.O.; Øverland, M.; Skrede, A.; Hansen, J.Ø. Yeast as major protein-rich ingredient in aquafeeds: A review of the implications for aquaculture production. Rev. Aquac. 2021, 13, 949–970. [CrossRef]
Hezarjaribi, M.; Ardestani, F.; Ghorbani, R.H. Single cell protein production by Saccharomyces cerevisiae using an optimized culture medium composition in a batch submerged bioprocess. Appl. Biochem. Biotechnol. 2016, 179, 1336–1345. [CrossRef] [PubMed]
Jach, M.E.; Baj, T.; Juda, M.; S ́wider, R.; Mickowska, B.; Malm, A. Statistical evaluation of growth parameters in biofuel waste as a culture medium for improved production of single cell protein and amino acids by Yarrowia lipolytica. AMB Expr. 2020, 10, 35. [CrossRef] [PubMed]
Bazı ağır metallere (kadmiyum, kobalt, nikel) ve tuzluluğa (%12’ye kadar) dayanabilmektedir.



